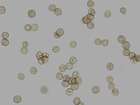
Mikromerkmale

Verwandte Arten
Cribraria argillacea (Pers.) Pers. 1794
Cribraria atrofusca G.W. Martin & Lovejoy 1932
Cribraria aurantiaca Schrad. 1797
Cribraria cancellata (Batsch) Nann.-Bremek. 1975
Cribraria confusa Nann.-Bremek. & Y. Yamam. 1983
Cribraria costata Dhillon & Nann.-Bremek. 1978
Cribraria dictydioides Cooke & Balf. f. ex Massee 1892
Cribraria dictyospora G.W. Martin & Lovejoy 1932
Cribraria elegans Berk. & M.A. Curtis 1873
Cribraria ferruginea Meyl. 1913
Cribraria filiformis Nowotny & H. Neubert 1993
Cribraria intermedia Schrad. 1797
Cribraria intricata Schrad. 1797
Cribraria languescens Rex 1891
Cribraria lepida Meyl. 1927
Cribraria macrocarpa Schrad. 1797
Cribraria macrospora Nowotny & H. Neubert 1993
Cribraria macrostipitata H. Neubert & Nann.-Bremek. 1977
Cribraria martinii Nann.-Bremek. 1964
Cribraria meylanii Brândză 1929
Cribraria microcarpa (Schrad.) Pers. 1801
Cribraria minutissima Schwein. 1832
Cribraria mirabilis (Rostaf.) Massee 1892
Cribraria montana Nann.-Bremek. 1973
Cribraria oregana H.C. Gilbert 1932
Cribraria atrofusca G.W. Martin & Lovejoy 1932
Cribraria aurantiaca Schrad. 1797
Cribraria cancellata (Batsch) Nann.-Bremek. 1975
Cribraria confusa Nann.-Bremek. & Y. Yamam. 1983
Cribraria costata Dhillon & Nann.-Bremek. 1978
Cribraria dictydioides Cooke & Balf. f. ex Massee 1892
Cribraria dictyospora G.W. Martin & Lovejoy 1932
Cribraria elegans Berk. & M.A. Curtis 1873
Cribraria ferruginea Meyl. 1913
Cribraria filiformis Nowotny & H. Neubert 1993
Cribraria intermedia Schrad. 1797
Cribraria intricata Schrad. 1797
Cribraria languescens Rex 1891
Cribraria lepida Meyl. 1927
Cribraria macrocarpa Schrad. 1797
Cribraria macrospora Nowotny & H. Neubert 1993
Cribraria macrostipitata H. Neubert & Nann.-Bremek. 1977
Cribraria martinii Nann.-Bremek. 1964
Cribraria meylanii Brândză 1929
Cribraria microcarpa (Schrad.) Pers. 1801
Cribraria minutissima Schwein. 1832
Cribraria mirabilis (Rostaf.) Massee 1892
Cribraria montana Nann.-Bremek. 1973
Cribraria oregana H.C. Gilbert 1932

Bitte klicken Sie die Karte für Details (für angemeldete Personen)
Cribraria aurantiaca Schrad. 1797
Synonyme: Cribraria persoonii Nann.-Bremek. 1971
Systematik: Eumycetozoa > Liceales > Cribrariaceae
Bitte registrieren Sie sich kostenlos auf den Seiten, damit Sie auf alle Informationen und Fundstellendaten zu den Arten Zugriff erhalten und die volle Funktionalität der internetseite nutzen können: